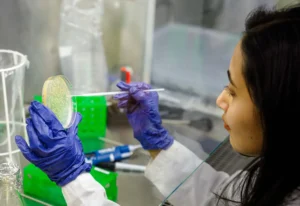

Video
Apraksts
Diabēta monitoringa jomā valstīs ar zemiem un vidējiem ienākumiem ir akūta nepieciešamība pēc pieejamiem, lētiem un precīziem risinājumiem, jo tieši tur dzīvo ap 80% no visiem pasaules diabēta slimniekiem. Pašlaik tirgū pieejamas nepārtrauktas glikozes monitoringa ierīces, taču tās ir dārgas un pārsvarā pieejamas pacientiem ar augstākiem ienākumiem. Uzticama alternatīva ir glikētā hemoglobīna (HbA1c) noteikšana, kas sniedz precīzāku priekšstatu par cukura līmeņa svārstībām asinīs ilgākā laika posmā. Projekta EXPEDIA mērķis ir izstrādāt enzīmu bāzētu biohibrīdo materiālu HbA1c ātrai un pieejamai kvantificēšanai asins paraugos. Lai gan fruktozilpeptīda oksidāzes (FPOX) enzīmi šim pielietojumam ir daudzsološi, pašlaik tie nespēj darboties ar veseliem glikētiem proteīniem. Tas nozīmē, ka HbA1c jāpārstrādā ar proteolītisko šķelšanu un jāveic sarežģīta paraugu sagatavošana, ko spēj nodrošināt tikai apmācīts personāls. Pašlaik tirgū nav pieejams uz strēmelēm balstīts FPOX tests. Projekts paredz izstrādāt jaunus FPOX enzīmu variantus ar platākiem pieejas kanāliem, kas spēj apstrādāt veselus proteīnus, un radīt sensoru lietotājam draudzīgai diabēta pašmonitoringa ierīcei.
Sasniedzamie rezultāti
Projekts paredz izstrādāt jaunus FPOX enzīmu variantus ar platākiem pieejas kanāliem, kas spēj apstrādāt veselus proteīnus, un radīt sensoru lietotājam draudzīgai diabēta pašmonitoringa ierīcei.
Ieguvums
Lietotājam draudzīga diabēta pašmonitoringa ierīce – potenciāli.
Piešķirtais finansējums
200 000 EUR no 13.10.2025.